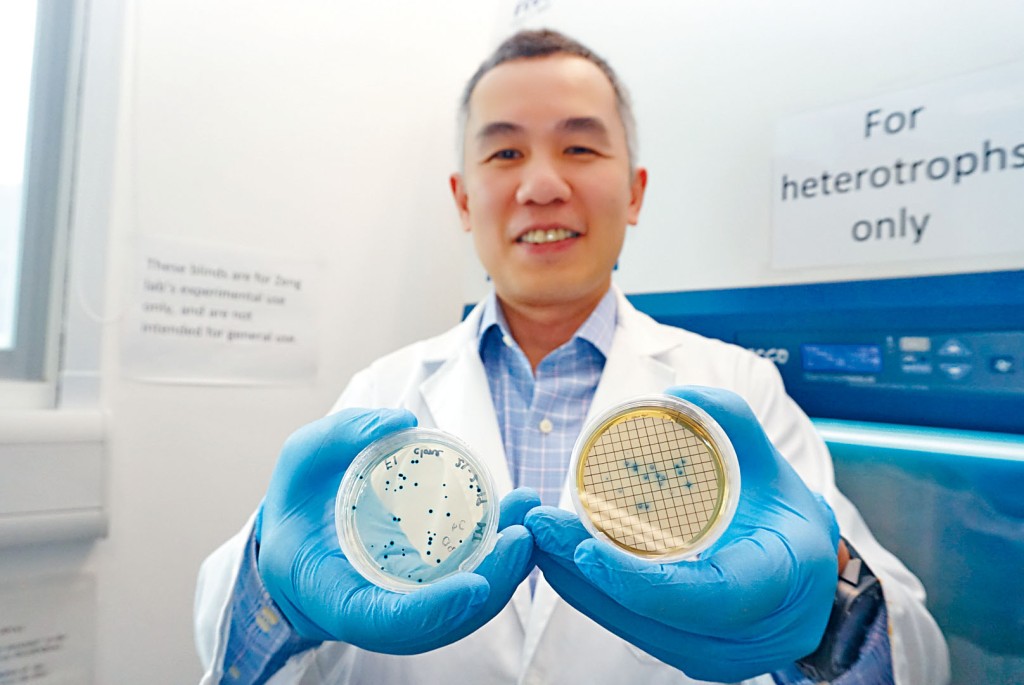
科大海洋科學系副教授劉振鈞發現，本港水域常見的「大腸桿菌」實際為近親二型，相信研究有助監測水質。

【教育要聞】港水域「大腸桿菌」 科大確認屬近親二型
更新時間:04:35 2019-07-22 HKT
發佈時間:03:00 2019-07-22 HKT
發佈時間:03:00 2019-07-22 HKT
(星島日報報道)大腸桿菌應用在分子生物已有半世紀,更是評估水質的主要指標。科技大學海洋科學系副教授劉振鈞花十年時間,成功確認本港水域常見的,能單獨於水中存活的「大腸桿菌」,實際為近親二型,並準備為其重新命名,有關研究已向科學期刊投稿,待審核後刊出。若研究成功審核後,將有助分析微生物於不同水域的習性和監測水質。
劉振鈞是土生土長的海洋學家,本科主修生物,碩士和博士都是在科大完成,大學二年級曾參加漁農自然護理署的實習計畫,評估科大對出水域成為海岸公園的影響,曾潛入水中觀察生物多樣性,繼而對海洋生態產生熱忱,更毅然投身科研,埋首研究香港水污染源頭近十年。
鍾情海洋生物研究的劉振鈞,完成科大博士學位後,為擴闊視野,自薦前往新加坡國立大學土木工程系攻讀博士後學位,主力研究污水處理中微生物系統;從香港研究海洋微生物轉到新加坡研究污水處理,跨學科的學習經驗為他日後回港研究大腸桿菌奠下基礎。
大腸桿菌近親二型雖然一般檢測表徵與大腸桿菌無異,但遺傳基因於一萬六千多年前已有別於大腸桿菌,大多在海洋生物腸臟發現。其實發現大腸桿菌近親二型實屬意外,劉振鈞在研究初期是專注污水中微生物源頭,大腸桿菌僅是他研究海水污染物源頭的指標之一。在一次細菌樣本實驗中,他發現樣本與大腸桿菌基因序列有別,部分竟可獨自存活於水中,初始懷疑只是菌囊損失,後發現為大腸桿菌近親之一,更是常見於香港鹹淡水水域。
大腸桿菌近親二型在外國早於〇五年已有文獻記載,但研究數據寥寥可數,劉振鈞在港發現大腸桿菌近親二型,為國際海洋微生物研究的一大進步,現正向科學期刊投稿發表,並嘗試依其生物特性為其正名,相信將有助分析微生物於不同水域的習性和監測水質。
劉振鈞坦言,現時對溫熱帶水域的研究不多,香港的海洋微生物的發展更是起步階段,但科研支援尚未足夠。他期望將來可設立水質監測中心,結合微電子技術等,實驗室可即時快速測試海水細菌樣本,大大提高準確度。另外,他表示海洋生態複雜,環環相扣,應盡可能減少不可逆的破壞,同時相信政府可參考科學家的專業意見,平衡環境保育和經濟發展。
劉振鈞是土生土長的海洋學家,本科主修生物,碩士和博士都是在科大完成,大學二年級曾參加漁農自然護理署的實習計畫,評估科大對出水域成為海岸公園的影響,曾潛入水中觀察生物多樣性,繼而對海洋生態產生熱忱,更毅然投身科研,埋首研究香港水污染源頭近十年。
鍾情海洋生物研究的劉振鈞,完成科大博士學位後,為擴闊視野,自薦前往新加坡國立大學土木工程系攻讀博士後學位,主力研究污水處理中微生物系統;從香港研究海洋微生物轉到新加坡研究污水處理,跨學科的學習經驗為他日後回港研究大腸桿菌奠下基礎。
大腸桿菌近親二型雖然一般檢測表徵與大腸桿菌無異,但遺傳基因於一萬六千多年前已有別於大腸桿菌,大多在海洋生物腸臟發現。其實發現大腸桿菌近親二型實屬意外,劉振鈞在研究初期是專注污水中微生物源頭,大腸桿菌僅是他研究海水污染物源頭的指標之一。在一次細菌樣本實驗中,他發現樣本與大腸桿菌基因序列有別,部分竟可獨自存活於水中,初始懷疑只是菌囊損失,後發現為大腸桿菌近親之一,更是常見於香港鹹淡水水域。
大腸桿菌近親二型在外國早於〇五年已有文獻記載,但研究數據寥寥可數,劉振鈞在港發現大腸桿菌近親二型,為國際海洋微生物研究的一大進步,現正向科學期刊投稿發表,並嘗試依其生物特性為其正名,相信將有助分析微生物於不同水域的習性和監測水質。
劉振鈞坦言,現時對溫熱帶水域的研究不多,香港的海洋微生物的發展更是起步階段,但科研支援尚未足夠。他期望將來可設立水質監測中心,結合微電子技術等,實驗室可即時快速測試海水細菌樣本,大大提高準確度。另外,他表示海洋生態複雜,環環相扣,應盡可能減少不可逆的破壞,同時相信政府可參考科學家的專業意見,平衡環境保育和經濟發展。
最Hit
公眾投選理大年度十大科研與創新故事 印證大學卓越創科成果 驅動香港醫療創新及AI+發展
2026-04-09 07:30 HKT
居深港漂曬落馬洲「守水塘」筍工 被公司發現後下場竟是... 哭訴:好日子徹底到頭
2026-04-09 14:58 HKT
只收現金=落後? 粥店事頭婆「神回覆」一句話竟獲食客力撐:呢個回應有啲勁 網民引2點力陳現金優勢
2026-04-09 15:32 HKT





























